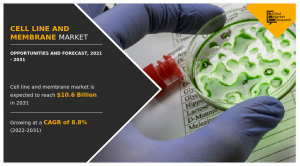
Cell Line and Membrane Market 2023

Cell Line and Membrane Market Size Poised to Reach USD 4.5 billion by 2031, Driven by Impressive 8.8% CAGR
PORTLAND, OREGON, UNITED STATES, May 29, 2023 /EINPresswire.com/ -- According to the report, the global cell line and membrane industry is estimated to generate $4.5 billion in 2021 and $10.6 billion by 2031, witnessing a CAGR of 8.8% from 2021 to 2031. The study analyzes the important strategies, drivers, competition, market dynamics, size, and important investment regions.
Key Takeaways:
Growing Demand: The cell line and membrane market is experiencing significant growth due to the increasing demand for cell-based therapies, drug discovery, and research in fields like cancer, immunology, and regenerative medicine. Cell lines serve as crucial tools for studying cellular behavior, disease mechanisms, and developing novel therapeutics.
Cell Line Diversity: There is a wide range of cell lines available in the market, including established cell lines and primary cell lines derived from various tissues and organisms. These cell lines offer researchers the ability to mimic specific physiological conditions and study cellular responses in a controlled environment.
Advancements in Technology: Technological advancements have improved the production, quality, and characterization of cell lines. Innovative techniques such as gene editing (e.g., CRISPR/Cas9) have enabled the generation of genetically modified cell lines with precise modifications, enhancing their utility in research and therapeutic applications.
Quality Control and Authentication: Ensuring the quality and authenticity of cell lines is crucial to avoid experimental errors and maintain reproducibility. Cell line authentication methods, such as DNA profiling, have gained importance to verify the identity and purity of cell lines, minimizing cross-contamination and misidentification issues.
Increasing Applications: Cell lines are utilized in a wide range of applications, including biopharmaceutical production, vaccine development, toxicity testing, disease modeling, and drug screening. Additionally, cell lines are instrumental in the production of recombinant proteins, monoclonal antibodies, and viral vectors used in gene therapies.
Request Sample Copy of the Report: https://www.alliedmarketresearch.com/request-sample/14227
Market Drivers:
Increasing Demand for Biopharmaceuticals: The demand for biopharmaceuticals, including monoclonal antibodies, recombinant proteins, and cell-based therapies, is rapidly growing. Cell lines play a critical role in the production of these biologics, driving the need for diverse and high-quality cell lines.
Advancements in Cell-Based Research: Cell lines are essential tools for studying cellular behavior, disease mechanisms, and drug discovery. Technological advancements, such as gene editing techniques like CRISPR/Cas9, have expanded the capabilities of cell lines, enabling the creation of genetically modified cell lines for targeted research and therapeutic applications.
Market Segmentation:
By Cell Line Type:
Continuous Cell Lines: Established cell lines that can be propagated indefinitely.
Primary Cell Lines: Cells derived directly from tissues or organs and have limited propagation potential.
Immortalized Cell Lines: Cell lines that have been genetically modified or transformed to bypass normal cellular senescence, allowing for prolonged propagation.
By Source:
Animal Cell Lines: Cell lines derived from animals, such as mice, rats, monkeys, and human cell lines.
Microbial Cell Lines: Cell lines derived from microbial sources, including bacteria and yeast.
Insect Cell Lines: Cell lines derived from insect species, commonly used in the production of recombinant proteins and vaccines.
By Application:
Biopharmaceutical Production: Cell lines used in the manufacturing of biopharmaceuticals, including monoclonal antibodies, recombinant proteins, and cell-based therapies.
Drug Discovery and Development: Cell lines employed in drug screening, target identification, and toxicity testing.
Disease Modeling: Cell lines used to mimic specific diseases or conditions for studying disease mechanisms and developing therapeutic interventions.
Regenerative Medicine: Cell lines utilized in tissue engineering, stem cell research, and cellular therapies.
By Membrane Type:
Filtration Membranes: Membranes used for filtration and separation processes, such as microfiltration and ultrafiltration.
Chromatographic Membranes: Membranes employed in chromatography-based separation techniques, including affinity chromatography and ion exchange chromatography.
Other Membranes: Additional membrane types used in cell culture, separation, and purification processes, such as dialysis membranes and reverse osmosis membranes.
By End User:
Research Institutes and Academic Centers
Biopharmaceutical Companies
Contract Manufacturing Organizations (CMOs)
Hospitals and Diagnostic Laboratories
Others (Biotechnology Companies, Government Organizations, etc.)
Request for Customization – https://www.alliedmarketresearch.com/request-for-customization/14227
Regional Growth Dynamics:
North America was the largest market in 2021, accounting for around two-fifths of the global cell line and membrane market, and is likely to lead the trail throughout the forecast period. This is due to the increase in the healthcare expenditure, a rise in the prevalence of cancer, growing demand for cell line for the development of therapeutic monoclonal antibodies and novel antibodies, and the presence of major players in this region. However, Asia-Pacific is anticipated to manifest the fastest CAGR of 9.8% during the forecast period, due to the rise in prevalence of chronic diseases, an increase in the geriatric population and an emerging economy in the region.
Competitive Landscape:
Thermo Fisher Scientific Inc.
Merck KGaA (known as MilliporeSigma in the United States and Canada)
GE Healthcare (a subsidiary of General Electric Company)
Lonza Group Ltd.
Corning Incorporated
Sartorius AG
Eppendorf AG
Danaher Corporation
Charles River Laboratories International, Inc.
Promega Corporation
Buy this Premium Research Report:
https://www.alliedmarketresearch.com/purchase-enquiry/14227
VALUE PROPOSITIONS RELATED TO THE REPORT:
Powered with Complimentary Analyst Hours and Expert Interviews with Each Report
Comprehensive quantitative and qualitative insights at segment and sub-segment level
Covid 19 impact trends and perspective
Granular insights at global/regional/country level
Deep-rooted insights on market dynamics (drivers, restraints, opportunities) and business environment
About Us:
Allied Market Research (AMR) is a full-service market research and business-consulting wing of Allied Analytics LLP based in Portland, Oregon. Allied Market Research provides global enterprises as well as medium and small businesses with unmatched quality of “Market Research Reports” and “Business Intelligence Solutions.” AMR has a targeted view to provide business insights and consulting to assist its clients to make strategic business decisions and achieve sustainable growth in their respective market domain.
Allied Market Research
Allied Market Research
+1 800-792-5285
email us here
Visit us on social media:
Facebook
Twitter
LinkedIn
Legal Disclaimer:
EIN Presswire provides this news content "as is" without warranty of any kind. We do not accept any responsibility or liability for the accuracy, content, images, videos, licenses, completeness, legality, or reliability of the information contained in this article. If you have any complaints or copyright issues related to this article, kindly contact the author above.